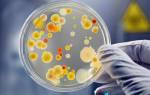

Сайт предоставляет справочную информацию исключительно для ознакомления. Диагностику и лечение заболеваний нужно проходить под наблюдением специалиста. У всех препаратов имеются противопоказания. Консультация специалиста обязательна!
Что значит хеликобактер (что представляет собой бактерия хеликобактер пилори)?
Хеликобактер пилори как бактериальная инфекция
Хеликобактер относится к бактериям – микроскопическим организмам, лишенным клеточного ядра. Бактерии представляют собой древнейшую форму жизни и широко распространены как в окружающей среде (их обнаруживали даже в жерлах вулканов), так и внутри человеческого организма.
Многие штаммы заселяющих человеческий организм бактерий просто необходимы для его существования – они вырабатывают многие полезные вещества, такие, к примеру, как витамин К, и защищают поверхности эпителия (кожи, желудочно-кишечного тракта, воздухоносных и мочеполовых путей) от воздействия патогенных микроорганизмов.
Однако существуют и крайне опасные виды бактерий, вызывающие смертельные инфекционные заболевания, такие как брюшной тиф, холера, чума, столбняк, газовая гангрена и др. Кроме того, бактерии являются виновниками таких грозных осложнений, как раневая и госпитальная инфекция, перитонит, септический эндокардит, инфекционно-токсический шок и сепсис.
Болезнетворные бактерии, к которым относится и хеликобактер пилори, обладают целым рядом признаков, отличающих их от безвредных микроорганизмов, в частности:
- генетически обусловленную способность к паразитированию (такие микроорганизмы, как правило, плохо приспособлены к выживанию во внешней среде);
- органотропность (приспособленность к поражению определенных органов и тканей);
- токсигенность (способность выделять ядовитые вещества, оказывающие болезнетворное действие на организм);
- специфичность (могут вызывать определенную инфекционную болезнь после проникновения в организм);
- способность к персистированию (способность длительное время сохраняться в организме, противодействуя защитным факторам иммунной системы).
История открытия бактерии хеликобактер пилори как виновника патологических процессов в желудке (гастрит, эрозия, язва желудка, рак)
Еще в конце позапрошлого, девятнадцатого века, многие ученые высказывали предположения, что возникновение таких заболеваний желудка как гастрит с повышенной кислотностью, язва и рак, связано с воздействием инфекции.
При этом некоторые исследователи публиковали данные об обнаруженных в слизи пораженного желудка бактериях характерной спиралевидной формы. Однако выявленные микроорганизмы, как принято говорить в научной среде, плохо культивировались инвитро.
То есть извлеченные микробы быстро погибали во внешней среде, поскольку на тот момент не существовало питательных сред, подходящих для их выживания и размножения. Данное обстоятельство стало препятствием к полноценному изучению обнаруженных спиралевидных бактерий.
Поэтому научные доказательства инфекционной природы гастрита с повышенной кислотностью (так называемый гастрит В , или хеликобактерассоциированный гастрит ), дуоденита и язвы желудка и двенадцатиперстной кишки были получены только через столетие, когда в 1983 году австралийские ученые Робин Уоррен и Барри Маршал поведали миру об уникальной находке – бактериях спиралевидной формы, обнаруженных в слизистом содержимом желудков больных с хроническим гастритом и пептической язвой.
Это было действительно выдающимся открытием в медицине, поскольку публикации столетней давности были забыты, и большинство гастроэнтерологов связывало развитие гастрита и пептической язвы желудка не с воздействием инфекции, а с такими факторами как неправильный режим питания, стрессы, употребление острой пищи, генетическая предрасположенность и др.
Оказалось, что обнаруженные бактерии принадлежат к новому, еще неизвестному медицине роду болезнетворных микроорганизмов, который с 1989 года начали называть Хеликобактер (Helicobacter), что в переводе с греческого означает спиралевидные бактерии.
На сегодняшний день, кроме открытого австралийскими исследователями возбудителя гастрита, дуоденита и пептической язвы – бактерии Helicobacter pylori (в буквальном переводе спиралевидная бактерия привратника (конечного отдела) желудка), обнаружено еще несколько видов хеликобактеров, некоторые из которых способны вызывать инфекционные заболевания у человека.
Бактерия хеликобактер пилори — фото
Микроб хеликобактер пилори как бактерия, приспособленная к существованию в антральном отделе желудка
Микроб хеликобактер пилори в основном обнаруживается в желудочных ямках под толстым защитным слоем слизи, которая выстилает внутреннюю поверхность желудка. Здесь сохраняется нейтральная среда с низким содержанием кислорода.
Микробов-конкурентов у хеликобактера пилори нет, а питательных веществ в желудочном содержимом более чем достаточно не только для поддержания численности популяции, но и для размножения.
Так что единственной проблемой желудочной бактерии является приспособление к своеобразным условиям среды и борьба с естественными защитными силами организма.
Спиралевидная форма хеликобактер пилори и наличие жгутиков позволяет бактерии быстро и ловко передвигаться штопорообразными движениями в желудочном соке и слизи, заселяя все новые участки.
При этом спиралевидная бактерия желудка выделяет фермент адаптации – уреазу , нейтрализующую соляную кислоту в непосредственной близости от хеликобактер пилори. Так что бактерия легко преодолевает кислую среду желудочного сока и достигает слизистого слоя целой и невредимой.
Кроме того, хеликобактер пилори выделяет вещества, позволяющие микробу ускользать от иммунного ответа хозяина. К примеру, адаптивный фермент каталаза расщепляет продуцированные активными нейтрофилами бактерицидные соединения кислорода на такие безвредные вещества, как кислород и вода.
От поглощения фагоцитами хеликобактер спасается при помощи ферментов, которые создают вокруг бактерии достаточную концентрацию аммиака, повреждающего внешние мембраны иммунных клеток, ответственных за уничтожение «чужаков».
Причины возникновения патологии при появлении бактерии хеликобактер пилори в желудке

- продуцирование токсических веществ и ферментов;
- активация воспалительных процессов;
- изменение физиологических параметров желудка.
Приблизительно 2/3 штаммов хеликобактер пилори вырабатывают так называемый вакуолизирующий цитотоксин – вещество, способствующее образованию вакуолей (ограниченных мембраной полостей внутри клетки) в эпителиальных клетках и последующей их гибели.
Повышенный износ поверхностных клеток эпителия желудка приводит к образованию эрозий. Как показали клинические исследования, именно штаммы, продуцирующие данный цитотоксин, обнаруживались у пациентов с пептической язвой и карциномой желудка. Кроме того, гибели эпителиальных клеток способствует повышенная концентрация аммиака, связанная с жизнедеятельностью хеликобактер пилори.
Продуцируемые хеликобактером ферменты фосфолипазы не только нарушают целостность мембран эпителиальных клеток, но и значительно снижают защитные функции желудочной слизи, способствуя повреждению поверхностных слоев эпителия.
Длительное персистирование хеликобактер пилори на слизистой оболочке желудка приводит к развитию хронической воспалительной реакции в виде незавершенного иммунного ответа на появление генетически чужеродного агента.
Некоторые медиаторы воспаления, такие, к примеру, как фактор активации тромбоцитов, способны вызывать изъязвления слизистой оболочки пищеварительного тракта.
Важнейшим фактором развития патологических процессов в антральном отделе желудка и двенадцатиперстной кишки является увеличение выработки пептидного гормона гастрина , повышающего секрецию желудочного сока.
Изменение физиологии желудка связано сразу с несколькими механизмами:
- Хеликобактер пилори выделяет адаптивные вещества, которые снижают кислотность желудочной слизи. Пониженный уровень кислотности воспринимается организмом как сигнал о недостаточной продукции желудочного сока. В результате повышается уровень гастрина и соляной кислоты.
- Воспалительные процессы в антральном отделе желудка сами по себе приводят к повышенной выработке гастрина.
- В норме продукция гастрина подавляется другим пептидным гормоном соматостатином . Установлено, что уровень соматостатина у пациентов с хеликобактер пилори значительно снижен.
Еще одним фактором, повышающим риск образования язв желудка и двенадцатиперстной кишки, является повышенная продукция пепсиногена , являющегося предшественником пепсина – желудочного фермента, расщепляющего белки. Увеличение уровня пепсиногена в крови, которое часто встречается у пациентов с хеликобактер пилори, в 30-50% случаев приводит к образованию язвы.
Хеликобактер пилори как причина развития язвы желудка — видео
Как передается инфекция хеликобактер пилори человеку?
Эпидемиология инфекции хеликобактер пилори (в каких группах населения наиболее часто происходит заражение)
Наиболее высокий уровень зараженности населения хеликобактер пилори регистрируется в развивающихся странах, где темп инфицирования у детей дошкольного возраста составляет около 10%, так что уровень зараженности у взрослого населения близок к 100%.
В цивилизованных странах заболеваемость у детей также значительно выше, чем у взрослых, однако уровень инфицированности хеликобактер пилори значительно ниже во всех возрастных категориях. При этом низкий социально-экономический статус остается важнейшим фактором риска заражения.
Поскольку для хеликобактер пилори характерно длительное, нередко бессимптомное персистирование в организме, уровень зараженности повышается с возрастом. По данным Маршала, первооткрывателя желудочной спиральной бактерии, в развитых странах хеликобактер обнаруживается у 20% лиц в возрасте старше 40 лет, а среди людей старше 60 лет процент инфицированных возрастает до 50%.
Как показали последние исследования, существуют и профессиональные риски заболевания хеликобактер пилори. Так, к примеру, постоянно общающиеся с пациентами гастроэнтерологи болеют значительно чаще представителей других профессий.
Как можно заразиться бактерией хеликобактер пилори (пути передачи)

Возбудитель заболевания выделяется из зараженного организма с каловыми массами, в то время как воротами инфекции является ротовая полость, куда хеликобактер пилори попадает с зараженными продуктами питания и водой.
У кишечных инфекций, заселяющих начальные отделы желудочно-кишечной трубки, есть еще и дополнительный путь передачи – орально-оральный .
Так, к примеру, хеликобактер пилори может выделяться из пораженного организма с рвотными массами и слюной. Однако такой путь передачи встречается редко и поэтому не имеет важного эпидемиологического значения.
И, наконец, существует еще и так называемый ятрогенный (буквально вызванный врачом) путь передачи, когда болезнетворная бактерия передается через неправильно обработанные инструменты во время проведения гастрофиброскопии и других медицинских манипуляций. К счастью, такой путь распространения хеликобактериоза также встречается не часто.
Откуда берется хеликобактер пилори (наиболее важные в эпидемическом отношении способы переноса инфекции от больного человека к здоровому)
Как и все болезнетворные бактерии, хеликобактер пилори плохо приспособлен к выживанию в окружающей среде. Поэтому большинство выделившихся из зараженного организма бактерий погибает, не сумев найти себе нового хозяина.
Лучше всего сохраняются хеликобактер пилори в холодной морской и пресной воде (могут выжить около двух недель). Поэтому заражение человека хеликобактериозом чаще всего происходит при употреблении недостаточно продезинфицированной питьевой воды.
Также значительную эпидемиологическую опасность представляют сырые овощи, в тех случаях, когда их полив производился из естественных или искусственных резервуаров со стоячей водой.
Можно ли заразиться хеликобактером пилори от животных?
Основным источником инфекции хеликобактер пилори является человек. Тем не менее, заразиться хеликобактериозом можно и от животных. Так, к примеру, среди работников скотобоен инфицированность хеликобактер пилори значительно выше, чем в общей популяции.
Опасными с эпидемиологической точки зрения в отношении хеликобактериоза являются такие виды животных как свиньи, обезьяны, домашние любимцы – собаки и кошки.
Передается ли желудочная бактерия хеликобактер через поцелуи?
Есть сведения о достаточно хорошей выживаемости хеликобактер пилори в человеческой слюне и зубном налете, так что заразиться хеликобактериозом можно и через поцелуи, а также при грубых нарушениях правил личной гигиены.
Так что следует объяснять детям, что нельзя делиться фруктами и сладостями по принципу «дай откусить», «дай лизнуть». Девочки-подростки должны знать, что совместное использование губной помады не только неэстетично, но и опасно.
Насколько заразен хеликобактер? Какие меры предосторожности следует предпринимать, чтобы не произошла передача инфекции в семье?

Хеликобактер пилори не передается через воздух, прикосновения, рукопожатия, общую одежду и игрушки (разумеется, если их не грызть). Достаточно лишь следить, чтобы все, что попадает в рот, соответствовало гигиеническим нормам.
Чтобы не заразить своих домашних, пациент с хеликобактер пилори должен придерживаться элементарных гигиенических норм, которые, кстати, не помешают и для профилактики других кишечных инфекций (мытье рук после туалета и перед тем, как прикасаться к пищевым продуктам, использование индивидуальной посуды и т.п.).
К сожалению, большинство случаев заражения в семье связаны с несоблюдением общепринятых правил сохранения здоровья. Так многие мамы инфицируют своих малышей, облизывая соску-пустышку, используя одну ложку на двоих и допуская другие виды милой на вид, но далеко не безопасной санитарной безграмотности.
Необходимо ли совместное лечение в тех случаях, когда у одного из членов семьи положительный анализ на хеликобактер пилори?
От чего появляется хеликобактер у собак? Как узнать, заразен ли наш домашний любимец?

Основным признаком вызванных хеликобактером пилори гастритов у собак и кошек является рвота животных. Но данный симптом неспецифичен и встречается и при многих других заболеваниях, так что при появлении признаков «желудочной» болезни у домашнего животного следует пройти ветеринарное исследование.
У собак, также как и у людей, распространено здоровое носительство хеликобактер пилори – то есть ситуация, когда болезнетворная бактерия обитает в организме, не доставляя «хозяину» каких-либо неудобств. В таких случаях решение о эрадикации хеликобактер пилори принимает ветеринар совместно с хозяевами домашнего любимца.
Следует отметить, что домашние собаки и кошки могут быть носителями многих опасных для человека заболеваний, поэтому их хозяевам следует не только следить за здоровьем своих подопечных, но и соблюдать гигиенические нормы, необходимые для безопасности всех членов семьи.
Как часто заражаются хеликобактер пилори повторно?
Как следует из результатов статистических исследований, частота повторного заражения в первый год после успешно проведённой эрадикации (ликвидации) хеликобактер пилори составляет от 5 до 35% (по разным данным). В дальнейшем ежегодный процент повторного инфицирования значительно снижается (до 3% в первый же год).
Существует предположение, что высокий процент повторного инфицирования в первый год связан с тем, что во многих случаях хеликобактер пилори не был полностью излечен. Так что цифры от 20% и выше связаны не с реинфекцией, а с обострением недолеченного хеликобактериоза.
Статистические неточности связаны с тем, что после проведения антибактериальной терапии незначительная часть бактерий может сохраняться в других отделах желудочно-кишечного тракта (к примеру, на зубном налете в ротовой полости) и в дальнейшем повторно колонизировать желудок.
Заражение Helicobacter pylori является наиболее частой причиной гастрита, а также способствовать развитию язвы желудка и двенадцатиперстной кишки.
Что такое Helicobacter pylori?
Helicobacter pylori (также известная как H. pylori, хеликобактерная инфекция или Хеликобактер пилори) — мельчайшая бактерия в форме спирали, которая способна колонизировать слизистую оболочку желудка и двенадцатиперстной кишки, вызывая хронический гастрит и язву желудка.
Бактерии вида Helicobacter pylori имеют продолговатую форму, которая может быть изогнутой или спиралевидной. На одном конце они несут нитевидные клеточные отростки (так называемые жгутики), которые они используют как своего рода пропеллеры для перемещения по слизистой желудка.
В слизистой Хеликобактер пилори находит оптимальные условия для жизни, потому что слизистая оболочка желудка защищает бактерии от агрессивной желудочной кислоты.

После заселения, бактерии Хеликобактер влияют на количество кислоты, выделяемой желудком. Вначале острой хеликобактерной инфекции продуцирование желудочной кислоты снижается и может оставаться низкой в течение недель или месяцев. Затем кислотность в желудке, как правило, снова нормализуется.
Однако при хронической инфекции Хеликобактер продукция кислоты в желудке у большинства больных наоборот увеличивается — только в редких случаях она ниже нормы.
Инфицирование данным микроорганизмом становится настоящей проблемой для современной медицины, ведь практически каждый второй взрослый человек является носителем бактерии, а, значит, имеет все риски для возникновения хронического воспаления в желудочно-кишечном тракте.
Частота встречаемости
Хеликобактер пилори встречается во всем мире. Вероятно, колонизация желудка этими бактериями начинается ещё в детстве.
В целом, чем старше человек, тем выше вероятность того, что он является переносчиком бактерии Хеликобактер.
В развивающихся странах около 80% людей в возрасте от 20 до 30 лет уже инфицированы бактерией Helicobacter pylori. В промышленно развитых странах, таких как Россия, заражение происходит реже из-за повышения уровня жизни. Тем не менее, каждый второй взрослый человек, в районе 50 лет, несет в себе этот тип бактерии.
Бактерии впоследствии могут быть причиной различных заболеваний желудочно-кишечного тракта:
- Гастрит: 80% всех хронических гастритов являются бактериальными и в основном развиваются в результате Хеликобактер.
- Язва желудка: колонизация бактериями Хеликобактер пилори обнаруживается в 75% всех случаев язв желудка.
- Язва двенадцатиперстной кишки: у 99% пациентов с язвой двенадцатиперстной кишки слизистая оболочка желудка колонизирована Helicobacter pylori.
- Рак желудка: Изменения в слизистой оболочке желудка могут способствовать развитию рака желудка. Риск развития рака желудка или некоторых желудочно-кишечных лимфом (в частности экстранодальной лимфомы маргинальной зоны) увеличивается при наличии инфекции Хеликобактер пилори.
Как передается Хеликобактер пилори?
Заразиться Helicobacter pylori может как взрослый, так и ребенок. Основным путем передачи является фекально-оральный, таким образом болезнь причисляется к кишечным инфекциям, наряду с брюшным тифом или дизентерией. Продукты питания и вода, зараженные каловыми массами больного, могут стать источниками заражения.
Другой немаловажный путь инфицирования – орально-оральный, то есть посредством слюны. Ранее гастрит, вызванный бактерией, именовался «болезнью поцелуев», что подчеркивает важность соблюдения правил личной гигиены и исключение использования зубных щеток или губных помад других людей.
Редкий путь передачи инфекции – ятрогенный (буквально – «спровоцированный врачом») или контактный. Недостаточная стерилизация фиброгастроскопов, которые предназначены для процедуры ФГДС, может привести к колонизации Helicobacter pylori в организме ранее здорового человека.
Попадая в организм через ротовую полость, бактерия надежно прикрепляется к слизистой оболочке антрального отдела кишечника. Защитные силы кислого желудочного сока и местные макрофагальные факторы не могут противостоять Хеликобактер пилори, бактерия вырабатывает специфические нейтрализующие ферменты.
Выброс большого количества гастрина и ионов водорода повышают кислотность среды желудка, которая является сильным агрессором для нежной слизистой. Помимо этого, специфические цитотоксины обладают прямым повреждающим действием на клетки слизистой, вызывая эрозии и язвы. К тому, же бактерию Хеликобактер можно охарактеризовать как инородного агента, на который организм реагирует в виде хронической воспалительной реакции.
Провоцирующие факторы заболевания
Несмотря на высокую вирулентность (то есть способность к заражению) Хеликобактер пилори имеется ряд факторов риска, которые значительно повышают риск развития дальнейших хронических заболеваний:
- хронический стресс;
- нерациональное питание и недостаток сна;
- курение;
- чрезмерное употребление алкоголя, кофе;
- наличие хронических заболеваний сахарный диабет, анемия, подагра);
- длительное лечение противоопухолевыми препаратами в анамнезе;
- склонность к желудочной гиперсекреции частые приступы изжоги);
- необходимость в частом приеме нестероидных противовоспалительных средств (Аспирин, Диклофенак, Индометацин).
Также можно выделить другие хронические заболевания желудка, которые усугубят клиническое течение хеликобактерной инфекции:
- аутоиммунный гастрит;
- неинфекционный гранулематозный гастрит;
- аллергический эозинофильный гастрит;
- инфекционный грибковый или вирусный гастрит.
Как развивается бактерия
Хеликобактер пилори развивается по двум стадиям:
- Начальная стадия. Первые симптомы заболевания могут длительное время не давать о себе знать. Легкая изжога и боль в эпигастрии не вызывают у большинства людей чувства опасения за свое здоровье.
- Развернутая стадия. Время наступления этой стадии индивидуально для каждого пациента и зависит от реактивности организма. Похудание без видимых причин, патологическое изменение аппетита (повышение или снижение) и нарастание явлений диспепсии могут свидетельствовать о бурном развитии заболевания.
Признаки заражения бактерией
Острая хеликобактерная инфекция
Симптомы острой хеликобактерной инфекции можно объединить понятием «желудочная диспепсия», то есть нарушение пищеварения в желудке. Обнаружить у себя Хеликобактер пилори можно по следующим признакам:
- изжога – неприятное чувство жжения за грудиной, усиливающееся при наклоне туловища или в положении лежа на спине;
- отрыжка кислым;
- боль в эпигастральной области (в верхней части живота), возникающая через 2 часа после приема пищи;
- вздутие живота, склонность к метеоризму и запорам;
- тяжесть в животе;
- тошнота;
- рвота кислым содержимым желудка;
- снижение массы тела;
- уменьшение аппетита в связи со страхом приема пищи из-за болевого синдрома.
Если Хеликобактер у ребенка, или взрослого вызывает поражение двенадцатиперстной кишки, то можно заметить следующие симптомы заболевания:
- отрыжка горьким;
- появление тупой боли в области правого подреберья;
- спастический запор может смениться поносом.
У детей симптомы заболевания можно заметить только исходя из нарушения стула, ведь они могут не предъявлять других жалоб.
В некоторых случаях, особенно у детей, симптомы Хеликобактер пилори могут отобразиться на коже лица и всего тела в целом. Признаки на лице (см. фото выше) возникают в связи с развитием атопического дерматита – хронической аллергической реакции на присутствие инфекционного агента в организме:
- мелкие пузырьки, напоминающие ожог от листьев крапивы;
- красные или розовые пятна, возвышающиеся над поверхностью кожи;
- зуд кожи, приводящий к развитию ссадин и порезов, которые являются воротами присоединения вторичной инфекции.
Склонность к атопии (повышенной выработке иммуноглобулинов, которые отвечают за развитие аллергической реакции организма) зачастую является наследственным фактором. В связи с этим, следует обратить внимание на семейный характер проявления симптомов. Симптомы заболевания могут проявить себя именно кожными проявлениями, которые могут предшествовать развитию хронического гастродуоденита.
У людей старше 40 лет инфицирование Helicobacter pylori может сопровождаться появлением розацеа на лице (или розовых угрей). Прыщи локализуются преимущественно на носу, щеках, подбородке и лбу.
Некоторые ученые пытаются оспорить связь угревой сыпи и инфицирования Хеликобактером, однако, современная статистика указывают на то, что при лечение хеликобактерной инфекции антибиотиками проходит и угревая сыпь.
Хроническая хеликобактерная инфекция
Хроническая инфекция Helicobacter pylori часто протекает без симптомов. Если признаки и появляются, они обычно немного типичные, более общие жалобы на проблемы в верхней части живота (такие как изжога, вздутие живота после еды, частая отрыжка без специфических привкусов).
Возможные осложнения
Колонизация желудка бактериями Helicobacter pylori может привести к воспалениям слизистой оболочки желудка, а также перерасти в язву желудка и двенадцатиперстной кишки.
Также, в ряде запущенных случаев, длительный хронический атрофический гастрит одновременно с Хеликобактер пилори может привести к развитию рака желудка.
Диагноз: Как обнаружить Хеликобактер?
Выявить наличие Хеликобактер пилори – несложная задача. Анализы крови и исследование желудочной секреции помогут поставить диагноз на начальных этапах диагностики:
- лабораторные методы исследования;
- дыхательный тест на Хеликобактер – современный быстрый и высокоинформативный метод исследования. Основан на однократном приеме суспензии с мечеными молекулами углерода, которые расщепляются специфическими ферментами Helicobacter pylori. Через некоторое время меченый углерод в составе углекислого газа определяется в выдыхаемом воздухе посредством специального прибора.
Преимущество уреазного теста заключается в его неинвазивности, то есть пациенту не приходится сталкиваться с забором крови или проведением ФГДС.
- серологическое исследование (поиск антител против Хеликобактер в крови пациента). Норма в крови – полное отсутствие антител к бактерии. Метод примечателен тем, что помогает поставить диагноз на самых ранних стадиях;
- анализ кала. При помощи полимеразно-цепной реакции специалисты лаборатории могут найти следы антигенов бактерий в кале;
- общий анализ крови. На хроническую инфекцию могут косвенно указывать такие признаки, как анемия, повышение СОЭ и лейкоцитов;
- инструментальные методы исследования;
- ФГДС – эндоскопический метод исследования желудка и двенадцатиперстной кишки. Поможет увидеть признаки хронического гастродуоденита. При проведении ФГДС врач проводит биопсию слизистой оболочки желудка, мельчайший кусочек ткани отправляется в лабораторию, где изучается специалистами.
Биопсийный материал окрашивается специальными веществами и рассматривается в микроскопе на предмет существования в нем бактерий.
- исследование желудочной секреции путем зондирования желудка, поможет установить факт повышенной кислотности желудочного сока;
- рентгенография желудка. Контрастный метод исследования, который редко используется в диагностике. Поможет провести дифференциальную диагностику с раком и полипами желудка, а также установить локализацию мельчайших язв и эрозий.
Лечение Helicobacter pylori
Лечение Helicobacter pylori проводиться с помощью лекарств. Основой лечения является антибиотикотерапия, которая ведет к эрадикации (полному удалению) бактерии из организма.
Тройная терапия
Чаще всего бактерию лечат по следующей схеме (так называемая тройная терапия):
- Кларитромицин+Амоксициллин;
- Метронидазол+Тетрациклин;
- Левофлоксацин+Амоксициллин;
- ингибиторы протонной помпы (Омепразол, Омез или Пантопразол).
Вот вся и схема, тройной терапией она называется потому, что применяются 2 разных антибиотика и 1 препарат ингибитора протонного насоса.
Лечение антибиотиками обычно занимает около недели. Ингибиторы протонной помпы являются более важной частью терапии при заражении Helicobacter pylori, так как они снижают секрецию желудочной кислоты и, таким образом, повышают рН желудка (делают его менее кислотным), что помогает уничтожать бактерии.
Поэтому ингибитор протонной помпы обычно принимается дольше, чем антибиотики, в общей сложности около четырех недель — дозировку после каждой недели понижают.
Дополнительно могут назначаться:
- Де-Нол. Препарат, создающий защитную пленку на слизистой оболочке желудка;
- Пробиотики. Длительный прием антибиотиков может привести к дисбактериозу. Поэтому пациент принимает Аципол, Линекс и другие препараты, нормализующие микрофлору желудочно-кишечного тракта.
Избавиться от хеликобактер пилори навсегда – возможно, благодаря четкой схеме лечения.
Народные методы лечения
Снижение кислотности желудочного сока поможет значительно снизить симптомы изжоги, тошноты, рвоты и отрыжки.
- В качестве традиционных методов лечения рекомендуется применять по одной чайной ложке отвара льняного масла перед едой, который еще и защитит слизистую оболочку желудка. Для приготовления отвара следует нагреть льняное масло, а затем профильтровать. Полученная густая масса готова к употреблению.
- Другой метод – отвар из зверобоя и ромашки, который также следует применять за 30 минут до еды. Для приготовления отвара достаточно взять по 2 столовые ложки трав и залить их горячей водой. После того, как раствор остудился, следует хранить его в темной таре в холодильнике не более 7 дней. Иначе он потеряет свои полезные свойства.
- Настой из земляники или листьев брусники позволит справиться с выраженным болевым синдромом и окажет мягкое спазмолитическое действие. Бруснику удобнее всего использовать в форме индивидуальных фильтр-пакетиков. Для лучшего сохранения полезных веществ не рекомендуется использовать кипящую воду.
Однако, полное удаление бактерии из организма возможно только благодаря рациональной антибиотикотерапии.
Диета
Рациональное питание при инфицировании бактерией имеет свои особенности:
- следует соблюдать температурный режим употребляемой пищи – она должна быть теплой;
- тщательно пережевывать пищу;
- избегать грубоволокнистую пищу, отдавая предпочтение супам и пюре;
- пить не менее двух литров чистой негазированной воды;
- есть небольшими порциями 5-6 раз в день.
Продукты, которых следует избегать:
- жирное мясо, рыбу;
- копчености;
- острое;
- продукты, жареные на большом количестве масла и во фритюре;
- цитрусы, шоколад и кофе, раздражающие стенку желудка;
- алкоголь;
- фастфуд;
- выпечку;
- грибы;
- газированные напитки;
- маринованные и соленые продукты.
Строгой диете рекомендуется придерживаться на протяжении 1-2 месяцев от начала лечения.
https://youtube.com/watch?v=AJY3kFZH0Aw
Профилактика и рекомендации
Избежать инфицирования бактерией достаточно сложно. По последним данным, риск заражения Helicobacter pylori членов семьи инфицированного человека составляет 95%.
Следует воздействовать на факторы риска (отказаться от курения и алкоголя, избегать стресса, не допускать повышения массы тела) и соблюдать правила личной гигиены (не пользоваться общими зубными щетками, помадами).
Если инфицирования не удалось избежать, то вовремя проведенная эрадикационная терапия поможет навсегда забыть о бактерии.
Прогноз
Прогноз хеликобактерной инфекции считается благоприятным. Бессимптомное носительство и легкие формы заболевания могут лишь наименьшим образом навредить здоровью пациента.
Неприятные симптомы желудочной диспепсии, боль после приема пищи и связанный с этим страх еды могут значительно снизить качество жизни и трудоспособность пациента.
Редко возникающие запущенные стадии заболевания могут привести к тяжелым последствиям – развитию глубоких язв желудка и их перфорации. В таком случае высок риск развития перитонита (воспаления брюшины) и жизнеугрожающего состояния шока.
Аденокарцинома (рак желудка), возникающий на фоне атрофического гастрита, может привести к инвалидизации пациента.
https://youtube.com/watch?v=-ti2X7dI8zM
Бактерия Хеликобактер пилори стала известна не так давно. Не все заболевшие знают, что являются носителем паразита. С бактерией жить можно, но ее наличие в организме ухудшает качество жизни. Как можно заразиться Хеликобактер пилори и насколько она опасна, необходимо знать каждому человеку, чтобы защитить себя и близких.
О бактерии
В 1979 году появилась гипотеза, что заболевания ЖКТ появляются вследствие жизнедеятельности некой бактерии, проживающей внутри человека. Название состоит из двух частей: «хелико» говорит о том, что бактерия спиральной формы, а «пилори» указывает на отдел желудка, в котором она обитает.
Многие бактерии не выживают в кислой среде желудка, но это не касается данной бактерии. Она прекрасно себя чувствует и нейтрализует кислоту. Из-за этого в желудке могут развиваться другие паразиты.
Внешне бактерия напоминает спираль со жгутиками. Она перемещается по стенкам желудка или закрепляется на внутренней оболочке. Чтобы понимать, как можно заразиться бактерией Хеликобактер пилори в быту, необходимо знать способы передачи.
Пути передачи
Путей передачи заболевания может быть несколько. Но важно понимать, что бактерия не живет в воздухе. Нельзя заразиться в помещении, в котором находится больной, если не взаимодействовать с ним. Можно ли заразиться Хеликобактер пилори в местах массового скопления людей? Можно, но для этого должны «выполняться» следующие условия:
- Несоблюдение правил гигиены. Отсутствие привычки мыть руки после туалета, после улицы, перед едой увеличивает риск заражения в несколько раз.
- Снижение защитных сил организма. Сильный иммунитет позволит избежать заражения или не даст бактерии активно размножаться.
Основным способом заражения считается фекально-оральный. Но можно ли заразиться Хеликобактер пилори через поцелуй? Такая вероятность тоже есть.
Существует несколько способов передачи бактерии бытовым путем:
- при поцелуе, соприкосновении слизистых оболочек здорового и инфицированного человека;
- при использовании в пищу неочищенной воды, бактерия способна жить в воде до нескольких недель;
- через некачественно обработанные инструменты в медицинских учреждениях;
- при несоблюдении чистоты рук;
- через общую посуду, ложку, соску и т.д.
Существует предположение, что в мире инфицировано около 70 % населения. Но далеко не всех обследуют на носительство бактерии. Медикам известно, как можно заразиться Хеликобактер пилори. В странах третьего мира заражено большее количество людей, чем в развитых странах.
Симптомы заболевания
Хеликобактер пилори может десятилетиями никак не проявлять себя. Но существуют признаки, при появлении которых врач должен отправить пациента на сдачу анализов:
- отвратительный запах изо рта;
- боли в желудке;
- периодическая тошнота;
- часто появляющаяся изжога;
- изменения стула;
- высыпания на коже;
- привкус во рту, усиливающийся после еды.
Кожа является индикатором состояния желудочно-кишечного тракта. Поэтому при появлении высыпаний, сухости кожи следует пройти обследование для исключения заражения бактерией. Чаще всего присутствуют следующие проявления:
- потрескавшаяся кожа на пальцах рук и ног;
- атопический дерматит;
- воспаление кожи лица.
После проведенного лечения проблемы с кожей проходят сами. Если местное лечение кожи не приносит результата, следует провести обследование на Хеликобактер. Чтобы исключить заражение в дальнейшем, необходимо знать, как можно заразиться Хеликобактер пилори.
Как обнаружить болезнь
Правильная и своевременная диагностика позволит избежать множества проблем. Для выявления заболевания необходимо использовать методы, применяемые в современной медицине:
- анализ кала позволит довольно точно выяснить наличие бактерии в организме;
- дыхательный тест можно использовать для диагностики детей, беременных женщин и всех остальных пациентов;
- анализ крови из вены на определение антител к Хеликобактер пилори не дает основания для назначения лечения, но требует дополнительного дообследования пациента;
- эндоскопическое обследование желудка — наиболее точный метод для выявления заболевания, но имеет ряд противопоказаний.
У каждого способа диагностики есть преимущества и недостатки. Эндоскопия довольно неприятная процедура, но имеет высокую точность и быстрый результат. Не проводится у беременных женщин и детей.
Анализ крови на антитела может выдавать повышенные титры после лечения. Дело в том, что антитела в крови сохраняются длительное время. Поэтому при положительном результате требуется дополнительное обследование.
Осложнения
Бактерия Хеликобактер пилори опасна тем, что может провоцировать острые и хронические заболевания ЖКТ. Поэтому требуется своевременная терапия, позволяющая исключить осложнение и инфицирование окружающих людей.
Для заболевшего человека увеличивается риск развития болезней:
- гастрита;
- язвы желудка и двенадцатиперстной кишки;
- развития онкологии;
- заболеваний, вызванных разрушением слизистой желудка.
Для исключения патологии необходимо проводить лечение под наблюдением грамотного гастроэнтеролога.
Лечение болезни
Пациент знает, как можно заразиться Хеликобактер пилори, лечение должен назначить врач. Полное выздоровление происходит не быстро, требуется терпение и соблюдение рекомендаций врача. Назначать лечение самостоятельно недопустимо, т.к. терапия может не принести результат, а за это время болезнь прогрессирует.
Лечение не всегда требуется после обнаружения бактерий. Если в ходе обследования выявили небольшое количество бактерии в желудке и это никак не отражается на качестве жизни, то лечение можно отложить. При выявленных осложнениях и заболеваниях ЖКТ лечение назначается обязательно.
В лечении назначается два антибиотика и препарат для снижения кислотности желудка. При наличии воспаления применяют препараты, позволяющие снизить действие соляной кислоты на поврежденные участки. Ингибиторы протонной помпы заживляют эрозию и снижают кислотность желудка. Все препараты не влияют на способность антибиотика бороться с бактериями.
Во время лечения больному требуется соблюдать диету. За основу взять принципы здорового питания:
- есть часто и понемногу;
- отказаться от жареного, копченого, мучного;
- выпивать 1,5-2 литра воды ежедневно;
- не курить;
- не пить алкогольные и газированные напитки;
- отказаться от вредной пищи и перекусов на ходу.
Также в лечении используют блокаторы протонной помпы. К наиболее популярным относятся:
Данные препараты помогают восстановить поврежденный желудок и усиливают действие антибиотиков. При появлении результата использование блокаторов позволяет усилить действие противомикробных препаратов и уменьшить дозу антибиотика.
Нужен ли антибиотик
Для предотвращения заболевания окружающие должны знать, как можно заразиться Хеликобактер пилори и как его лечить. Одним из компонентов лечения является применение антибиотиков. И если появляются сомнения, требуется ли антибиотик при лечении бактериального заболевания, то их необходимо отбросить.
При лечении Хеликобактер пилори используют одновременно 2 антибиотика. Дело в том, что бактерия довольно устойчива к лекарствам. Лечение должно проходить согласно инструкции в соответствии с назначенной схемой. При непереносимости антибиотика или появлении побочных эффектов необходимо обратиться к врачу.
Возможно ли заразиться повторно
Можно ли повторно заразиться Хеликобактер пилори? По результатам исследований частота повторного заражения в течение первого года после проведенного лечения составляет 20 %. Есть вероятность, что статистика не учитывает лечение, которое не привело к полному уничтожению бактерии.
Также существует предположение, что бактерии сохраняются в других отделах ЖКТ, откуда в дальнейшем мигрируют, следовательно, Хеликобактер пилори можно заразиться повторно.
Иммунитет к Хеликобактер пилори не вырабатывается. Следовательно, повторное заражение приведет к появлению симптомов заболеваний ЖКТ, если они проявлялись раньше.
Профилактика заражения Хеликобактер пилори
Защититься полностью от болезни невозможно, т.к. заражение может произойти где угодно. Но существует ряд мероприятий, снижающих риск инфицирования бактериями:
- соблюдение гигиены позволяет не заразиться многими инфекционными болезнями;
- укрепление иммунитета увеличивает вероятность того, что организм самостоятельно справится с бактерией на этапе заселения в организм;
- регулярная диагностика ЖКТ и проведение обследований позволят распознать болезнь на ранних стадиях, что позволит провести более легкое лечение.